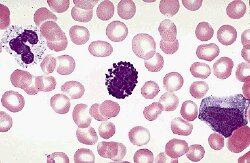

Investigadores descubrieron una mutación genética común en más de la mitad de los casos de una forma agresiva de leucemia infantil.
El hallazgo, dicen los investigadores en su estudio en la revista Science , señala que un grupo de medicamentos que se utilizan para tratar el mal de Alzheimer, sería un buen candidato para tratar la leucemia.
Es un hallazgo promisorio, pues, si bien la leucemia linfoblástica aguda (LLA) se cura en alrededor del 75 por ciento de los casos con quimioterapia, el tratamiento resulta tóxico y deja a los niños vulnerables a otros problemas de salud.
El gen mutado es el Notch 1 , cuyo trabajo es controlar el desarrollo de los linfocitos T, células del sistema inmunitario que proliferan descontroladamente en este tipo de cáncer.
Resulta que la enzima gamma-secretasa, que separa a proteínas cerebrales involucradas en la enfermedad de Alzheimer, también ayuda a cortar al gen Notch 1 .
Investigadores de la enfermedad de Alzheimer han estudiado medicamentos que afectan a la gamma-secretasa.
“Podría ser útil estudiar cómo afectan dichos medicamentos a la LLA”, escribió el equipo de Weng en su estudio.
“El descubrimiento es significativo porque los inhibidores de la gamma-secretasa, un tipo de medicamentos que, se sabe, desactivan la actividad anómala del Notch 1 causada por la mutación, ya están en la línea de producción”, dijo el patólogo Jon Aster, autor del estudio.